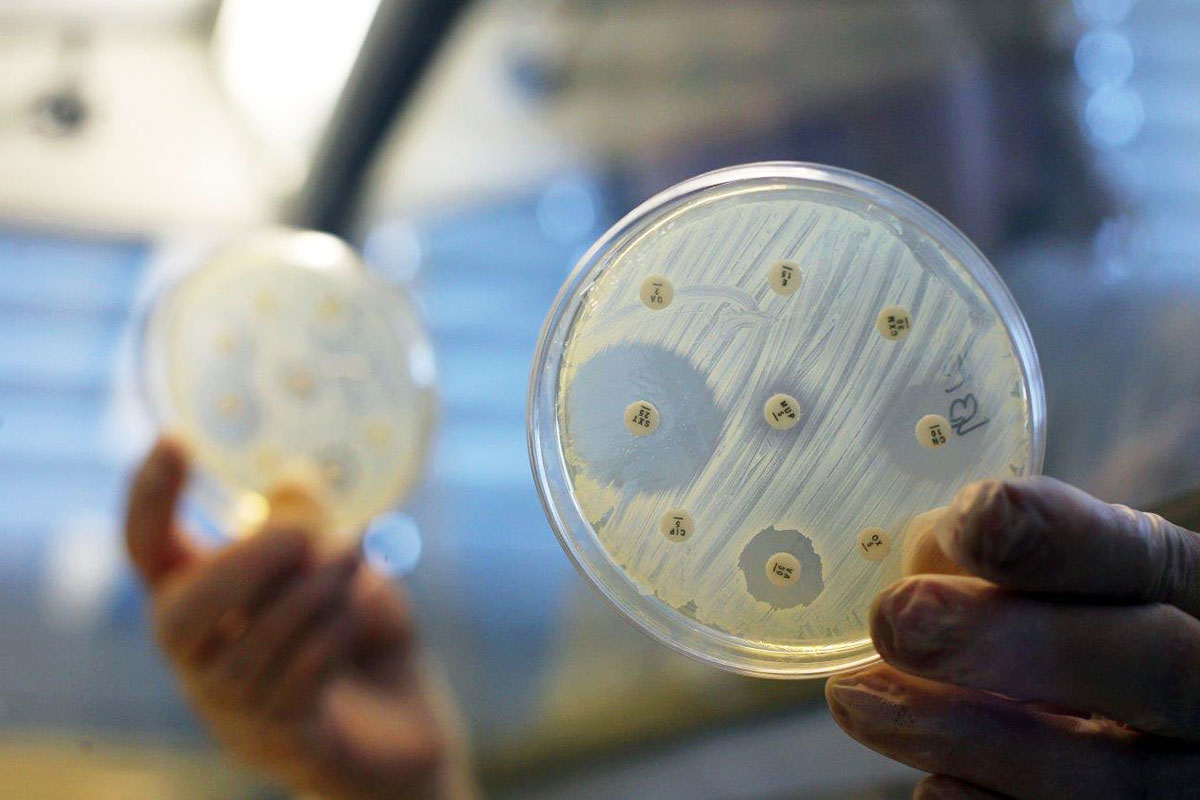
Bakterienkultur beim Test auf Antibiotika-Resistenz.

Multiresistente Bakterien sind vor allem als Verursacher von Krankenhausinfektionen gefürchtet. Sie kommen aber auch in Lebensmitteln vor. Eine Forschungs-Initiative nimmt die gefährlichen Erreger aus dem Supermarkt ins Visier.

Der Begriff „multiresistente Erreger“ taucht seit einigen Jahren immer öfter in den Medien auf, meist verbunden mit Krankenhausinfektionen. Bei diesen Erregern handelt es sich um Bakterien, die gegen mehrere Antibiotika resistent sind. Die Resistenzen führen dazu, dass Infektionen mit diesen Bakterien nur schwer oder gar nicht behandelt werden können. Die Folgen für die Betroffenen sind oftmals schwer. Nicht selten verlaufen solche Infektionen sogar tödlich.
Neue Forschungsansätze erforderlich
Bakterienkultur beim Text auf Antibiotika-Resistenz
HICARE, Danny Gohlke
Es besteht deshalb ein hoher Bedarf an neuen Produkten und Konzepten, um neue Resistenzen zu vermeiden, die vorhandenen Resistenzen zu umgehen und deren Ausbreitung einzudämmen. Hierzu unterstützt das Bundesforschungsministerium das Modellvorhaben „HICARE – Aktionsbündnis gegen multiresistente Bakterien“. HICARE ist eine von insgesamt fünf geförderten „Gesundheitsregionen der Zukunft“ in Deutschland. Das Projekt ist daher auch unter dem Synonym „Gesundheitsregion Ostseeküste“ bekannt. Das Ziel von HICARE ist es zu verhindern, dass sich multiresistente Erreger weiter ausbreiten. Hierzu werden unter anderem standardisierte Interventionen entwickelt, die unmittelbar in das Gesundheitssystem überführt werden sollen. Diese regional im äußersten Nordosten von Deutschland entwickelten Interventionen im Kampf gegen multiresistente Erreger können Vorbild für den Rest der Republik sein und anschließend deutschlandweit umgesetzt werden.
Lebensmittel im Visier

In bis zu jeder zweiten Geflügel- und Schweinefleischprobe wurden multiresistente Erreger nachgewiesen.
shutterstock - Kondor83
In der Gesundheitsregion HICARE beleuchten die Forscherinnen und Forscher den Umgang mit multiresistenten Erregern stets aus mehreren Richtungen. Dass ein veränderter Blickwinkel schnell neue Erkenntnisse an den Tag bringen kann, zeigt eine aktuelle Studie der Universitätsmedizin Greifswald. Die Arbeitsgruppe um Professor Dr. Ivo Steinmetz am Friedrich Löffler Institut für Medizinische Mikrobiologie hat sich mit multiresistenten Erregern in Lebensmitteln beschäftigt. „Zwar ist das Thema ‚Antibiotika in der Tierzucht und in Lebensmitteln‘ nicht gänzlich neu. Die Rolle von Nahrungsmittelketten bei der Verbreitung von multiresistenten Bakterien ist aber bisher unzureichend untersucht und möglicherweise unterschätzt worden“, sagt Steinmetz. So gibt es bislang kaum Erkenntnisse, welche Übertragungsmöglichkeiten und Gefahren hier für die Menschen bestehen.
Resistente Bakterien in Fleischprodukten
Die Arbeitsgruppe um Steinmetz befasst sich bereits seit mehreren Jahren mit dem Thema. In früheren Studien wurde eine zum Teil erhebliche Belastung von Hühnerfleisch mit multiresistenten Erregern wissenschaftlich dokumentiert. „In unserem laufenden Projekt haben wir das Spektrum auf weitere handelsübliche Fleischprodukte ausgedehnt, etwa auf Puten- und Schweinefleisch“, erklärt Steinmetz. Für die Studie wurden 400 Geflügel- und Schweinefleischproben in Berlin und Greifswald gekauft und im Labor untersucht. Hierbei handelte es sich sowohl um abgepackte wie auch um frische Waren. Das Ergebnis hat auch Steinmetz überrascht: „In bis zu jeder zweiten Probe konnten wir unmittelbar nach dem Kauf multiresistente Erreger nachweisen. Das ist mehr, als wir erwartet haben.“ Aber was bedeutet das nun für den Verbraucher? Besteht hier eine akute Gefahr? Hier relativiert der Wissenschaftler: „Wir wissen nicht, wie hoch die Übertragungswahrscheinlichkeit von Bakterien über kontaminierte Lebensmittel auf den Menschen ist. Auch die medizinische Bedeutung unseres Befundes ist bislang nicht klar. Das ist ein wichtiges Thema laufender Untersuchungen.“ Erwiesen ist damit vorerst nur, dass entsprechende Keime in den Produkten vorhanden sind. Dennoch ist dies eine äußerst wichtige Erkenntnis, denn sie macht eines ganz klar: Die Lebensmittelkette ist bei der Verbreitung von multiresistenten Erregern bislang nicht ausreichend im Fokus der Forschung gewesen. „Dies gilt nicht nur für Fleischprodukte, sondern auch für andere Nahrungsmittel, etwa Gemüse. Hier brauchen wir unbedingt weitere Erkenntnisse, um die Sachlage bewerten zu können“, resümiert Steinmetz.

Mit dem Ziel, multiresistente Krankenhauskeime einzudämmen, erarbeiten Wissenschaftlerinnen und Wissenschaftler der Gesundheitsregion HICARE unter anderem Hygieneleitfäden für Kliniken.
Thinstock - VILevi
Das Bundesforschungsministerium fördert insgesamt fünf Gesundheitsregionen. Sie bringen Expertinnen und Experten aus medizinischer Forschung, Entwicklung und Gesundheitsversorgung in einer Region zusammen. Hierdurch sollen Innovationen für das Gesundheitssystem entwickelt werden, die das Potenzial haben, sich auf ganz Deutschland übertragen zu lassen. Die Gesundheitsregion HICARE befasst sich mit dem Thema Antibiotika-Resistenz bei Bakterien. Neben den beiden Universitätskliniken in Greifswald und Rostock sind rund 40 weitere Partner involviert. Die Spannbreite reicht hierbei von kleineren Kreiskrankenhäusern und Reha-Zentren bis hin zu globalen Pharmaunternehmen. Gleichzeitig sind mehrere Krankenkassen sowie das Landesamt für Gesundheit und Soziales Mecklenburg-Vorpommern eingebunden. Gemeinsam werden beispielsweise Hygieneleitfäden für Kliniken erarbeitet, die von anderen Einrichtungen übernommen werden sollen. Für alle Forschungs-und Anwendungsgebiete werden daher auch Verwertungsstrategien entwickelt. So soll ein effizienter Transfer in die Praxis und damit in die alltägliche Gesundheitsversorgung erreicht werden.
Ansprechpartner:
Prof. Dr. Ivo Steinmetz
Universitätsmedizin Greifswald
Friedrich Loeffler Institut für Medizinische Mikrobiologie
Martin-Luther-Straße 6
17475 Greifswald
03834 865587
03834 865561
steinmetz.ivo@uni-greifswald.de